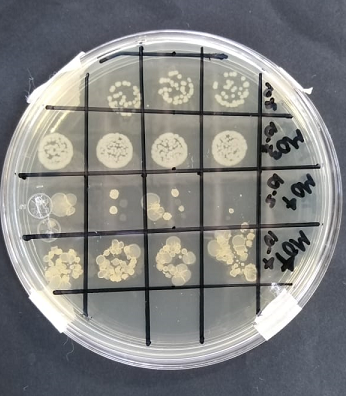

POLITÉCNICA EMPLEA MICROORGANISMOS PARA REMEDIACIÓN AMBIENTAL
27 junio, 2021Foto: IPN. Pruebas cinéticas bacterianas de tres cepas aisladas.
Fuente: IPN
Ante las afectaciones ambientales ocasionadas por el sector minero en Zacatecas, alumna del Instituto Politécnico Nacional (IPN) trabaja en una investigación que consiste en la identificación y aislamiento de microorganismos, cuyas características permiten la degradación de diversos metales principalmente el mercurio y cobre.
Abril Ibarra Colón, de la Unidad Profesional Interdisciplinaria de Ingeniería Campus Zacatecas (UPIIZ), analizó microorganismos para estudiar su resistencia en la degradación de metales pesados y sus potencialidades, para ser empleados en biorremediación y/o biolixiviación. Para ello, realizó una caracterización fisicoquímica de la muestra, basada en la NOM-021-SEMARNAT-2000, aisló los microorganismos con TSA (Agar de Soya Trípticaseina), para observar una posible tasa de crecimiento.
Seleccionó las cepas que crecieron en las primeras 72 hrs y se caracterizaron macro y microscópicamente, después se sometieron a estudios bioquímicos y de tolerancia de pH, y metales de interés a temperatura ambiente por 24 hrs, posteriormente se realizaron pruebas cinéticas bacterianas de tres cepas aisladas.
El comportamiento de la cinética de crecimiento de los microorganismos aislados, demostró una disminución a los cinco días, en la concentración de los metales disponibles en el medio para los ensayos realizados con mercurio y cobre. Los aislados mostraron resistencia a ciertos metales pesados, por lo que estos resultados muestran gran potencial para ser aplicados tanto a técnicas de lixiviación o biorremediación de suelos, con contenidos en metales pesados.
La importancia de su investigación radica en que el sector minero en México, es motor clave para el desarrollo económico, entre su producción destaca la plata, cobre, plomo, zinc y oro, “la entidad que más produce esto minerales es Zacatecas, pero esto también implica atender el impacto ambiental que genera esta actividad económica”.

